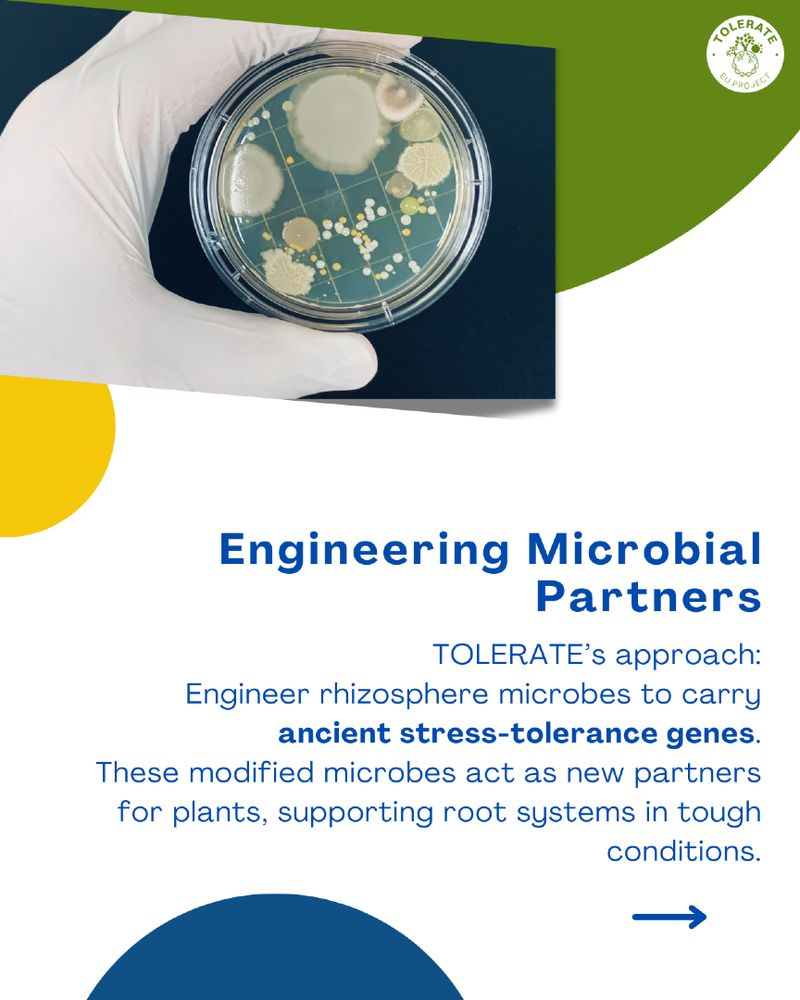

Funded by the European Union with the number 101082049. Views and opinions expressed are however those of the author(s) only and do not necessarily reflect those of the European Union.
In #TOLERATE , scientists engineer root-friendly microbes with resilience traits found in ancient soils, boosting water retention, nutrient uptake & heat/drought tolerance.

In #TOLERATE , scientists engineer root-friendly microbes with resilience traits found in ancient soils, boosting water retention, nutrient uptake & heat/drought tolerance.
Learn how the #TOLERATE Project studies bio-based molecules to boost crop resilience, support #ClimateAction & build trust in #biotech.
tolerate-eu-project.com/analyzing-bi...

Learn how the #TOLERATE Project studies bio-based molecules to boost crop resilience, support #ClimateAction & build trust in #biotech.
tolerate-eu-project.com/analyzing-bi...
Featuring our refreshed visual identity, it showcases the project’s objectives, consortium & social media channels, boosting visibility at upcoming events & conferences.
#EUprojects

Featuring our refreshed visual identity, it showcases the project’s objectives, consortium & social media channels, boosting visibility at upcoming events & conferences.
#EUprojects
Discover how the #TOLERATEproject is exploring microbial solutions to boost drought resilience in EU agriculture, sustainably and at scale.
👏 Great insights by Afnan Suleiman-Bioclear earth-
🔗 Read more: tolerate-eu-project.com/how-eu-toler...

Discover how the #TOLERATEproject is exploring microbial solutions to boost drought resilience in EU agriculture, sustainably and at scale.
👏 Great insights by Afnan Suleiman-Bioclear earth-
🔗 Read more: tolerate-eu-project.com/how-eu-toler...
🧬 Our session sparked great discussions around ancient DNA and how we can revive, through synthetic biology, lost functions beneficial for future agriculture.



🧬 Our session sparked great discussions around ancient DNA and how we can revive, through synthetic biology, lost functions beneficial for future agriculture.
Discover how life cycle thinking supports biotech innovation 🔗 https://bit.ly/46g7S9w Thanks to the Omnia team for their contribution!

Discover how life cycle thinking supports biotech innovation 🔗 https://bit.ly/46g7S9w Thanks to the Omnia team for their contribution!
Discover how we combine microbiome research for a more sustainable agri-food system.
Read the full press release👉https://tolerate-eu-project.com/communication-materials/

Discover how we combine microbiome research for a more sustainable agri-food system.
Read the full press release👉https://tolerate-eu-project.com/communication-materials/
Join Amedea Perfumo & @pabnik.bsky.social at #FEMS 2025 for a dynamic session🧬 "Something (very) old, something new: Innovative microbial solutions for sustainability challenges
🕦 15 July | 11:30–13:00 | Tower Lounge
🔗 femsmicro.org
▶️ youtu.be/0-bhcMpjJ_c
#TolerateEUProject

Join Amedea Perfumo & @pabnik.bsky.social at #FEMS 2025 for a dynamic session🧬 "Something (very) old, something new: Innovative microbial solutions for sustainability challenges
🕦 15 July | 11:30–13:00 | Tower Lounge
🔗 femsmicro.org
▶️ youtu.be/0-bhcMpjJ_c
#TolerateEUProject
#TOLERATE #HorizonEurope #Microbiology


#TOLERATE #HorizonEurope #Microbiology
Our latest TOLERATE article explores how outdated GMO/NGT rules could hinder progress.
Thanks to Mirta Alessandrini & Francesco Montanari for their legal insights.
👉 Read more: tolerate-eu-project.com/tolerate-agr...

Our latest TOLERATE article explores how outdated GMO/NGT rules could hinder progress.
Thanks to Mirta Alessandrini & Francesco Montanari for their legal insights.
👉 Read more: tolerate-eu-project.com/tolerate-agr...
Learn more: https://tolerate-eu-project.com/
#HorizonEurope #EUProjects #Biotechnology #SustainableAgriculture


Learn more: https://tolerate-eu-project.com/
#HorizonEurope #EUProjects #Biotechnology #SustainableAgriculture
❄️🌱Learn more: www.tolerate-eu-project.com

❄️🌱Learn more: www.tolerate-eu-project.com
New coordinator Pablo Ivan Nikel opened the meeting, presenting the transition and confirming that the project continues full speed ahead.
More info 👉 tolerate-eu-project.com
Subscribe 👉 eepurl.com/i6uufM
#EUProjects




New coordinator Pablo Ivan Nikel opened the meeting, presenting the transition and confirming that the project continues full speed ahead.
More info 👉 tolerate-eu-project.com
Subscribe 👉 eepurl.com/i6uufM
#EUProjects

